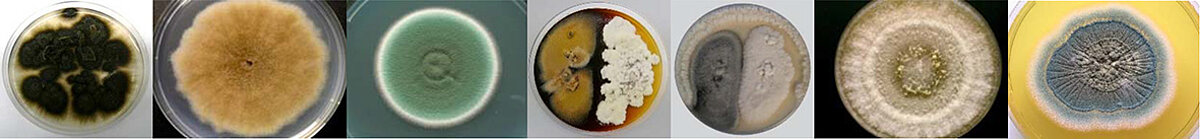

2nd International Conference of Marine Fungal Natural Products (MaFNaP_2017)
27-29 June, 2017, Kiel, Germany
The 2nd International Conference of the Marine Fungal Natural Products (MaFNaP) will be hosted by the GEOMAR Centre for Marine Biotechnology of the GEOMAR Helmholtz Centre for Ocean Research Kiel, Germany. It will take place at Wissenschaftszentrum Kiel on 27-29 June, 2017.
Invitation and call for papers
Fungi constitute an important proportion of marine microbiota. Marine fungi are a renewable and outstanding source for new bioactive natural products that can contribute significantly to the well-being of the society. However, their potential in many areas has largely remained untapped.
GEOMAR Centre for Marine Biotechnology (GEOMAR-Biotech), which is part of the Research Unit Marine Natural Products Chemistry of the GEOMAR Helmholtz Centre for Ocean Research Kiel (Germany) cordially invites you to the 2nd International Conference of the Marine Fungal Natural Products (MaFNaP) that will be held in Kiel (Germany) from 27-29 June 2017. This event will gather an international audience to discuss new developments and approaches within the field, enhance awareness on marine fungi as a sustainable resource for blue biotechnology and highlight the potential of marine fungal metabolites in various areas. It also serves as a forum for networking and promotion of young scientists working in the field.
Abstracts will be considered for short talks or poster presentation. Selected posters will also be given the opportunity to be presented during short flash presentations.
This conference is organised in collaboration with the European Society for Marine Biotechnology.
Confirmed Speakers
Prof. Dr. Russell Kerr, University of Prince Edward Island, Canada
Prof. Dr. Anake Kijjoa, University of Porto, Portugal
Prof. Dr. Vera Meyer, Berlin University of Technology, Berlin, Germany
Prof. Dr. Frank Kempken, Kiel University, Germany
Prof. Dr. Nina Gunde-Cimerman, University of Ljubljana, Slovenia
Prof. Dr. Johannes F. Imhoff, GEOMAR Helmholtz Centre for Ocean Research Kiel, Germany
Dr. Marlis Reich, University of Bremen, Germany
Dr. Catherine Roullier, University Nantes, France
Prof. Dr. Eva Stukenbrock, Kiel University and Max Planck Institute for Evolutionary Biology Plön, Germany



